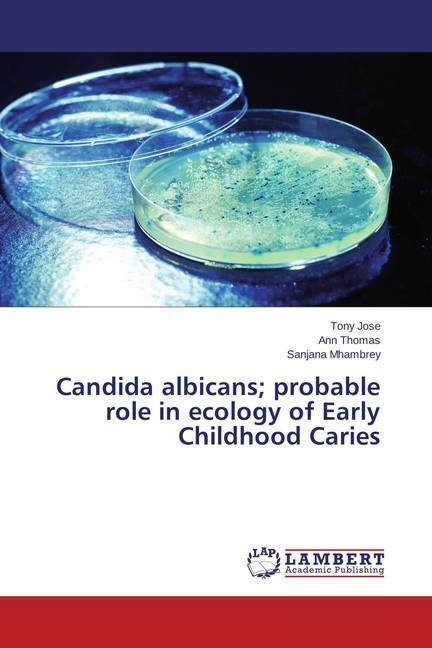

- Afhalen na 1 uur in een winkel met voorraad
- Gratis thuislevering in België vanaf € 30
- Ruim aanbod met 7 miljoen producten
- Afhalen na 1 uur in een winkel met voorraad
- Gratis thuislevering in België vanaf € 30
- Ruim aanbod met 7 miljoen producten
Zoeken
Candida albicans; probable role in ecology of Early Childhood Caries
Tony Jose, Ann Thomas, Sanjana Mhambrey
Paperback | Engels
€ 55,95
+ 111 punten
Omschrijving
Early Childhood Caries (ECC), a rampant type of dental caries in children below 71 months of age; a chronic childhood disease with a severe sequalae affecting the child and family. It is a multifactorial disease, with S.mutans and Lactobacilli being implicated as the main microorganisms in its etiopathogenesis. Recent literature suggests a probable role of Candida, fungal species, a normal commensal of the oral cavity, in its etiopathogenesis. Under particular predisposing physiological or pathological conditions, Candida is capable of provoking pathologies via endogenous infectious mechanism. In early childhood period, due to immature immune system and not fully established microflora in the oral cavity, children are more susceptible to opportunistic microbial colonization. This book covers a pre-school cross-sectional study to determine the Candida albicans counts, forms of existence and acidogenic potential; and to correlate its role with Streptococcus mutans, Streptococcus sanguinis and Lactobacilli levels in children with ECC, S-ECC and caries free.
Specificaties
Betrokkenen
- Auteur(s):
- Uitgeverij:
Inhoud
- Aantal bladzijden:
- 96
- Taal:
- Engels
Eigenschappen
- Productcode (EAN):
- 9783659229176
- Verschijningsdatum:
- 10/02/2015
- Uitvoering:
- Paperback
- Afmetingen:
- 150 mm x 220 mm
- Gewicht:
- 150 g

Alleen bij Standaard Boekhandel
+ 111 punten op je klantenkaart van Standaard Boekhandel
Beoordelingen
We publiceren alleen reviews die voldoen aan de voorwaarden voor reviews. Bekijk onze voorwaarden voor reviews.